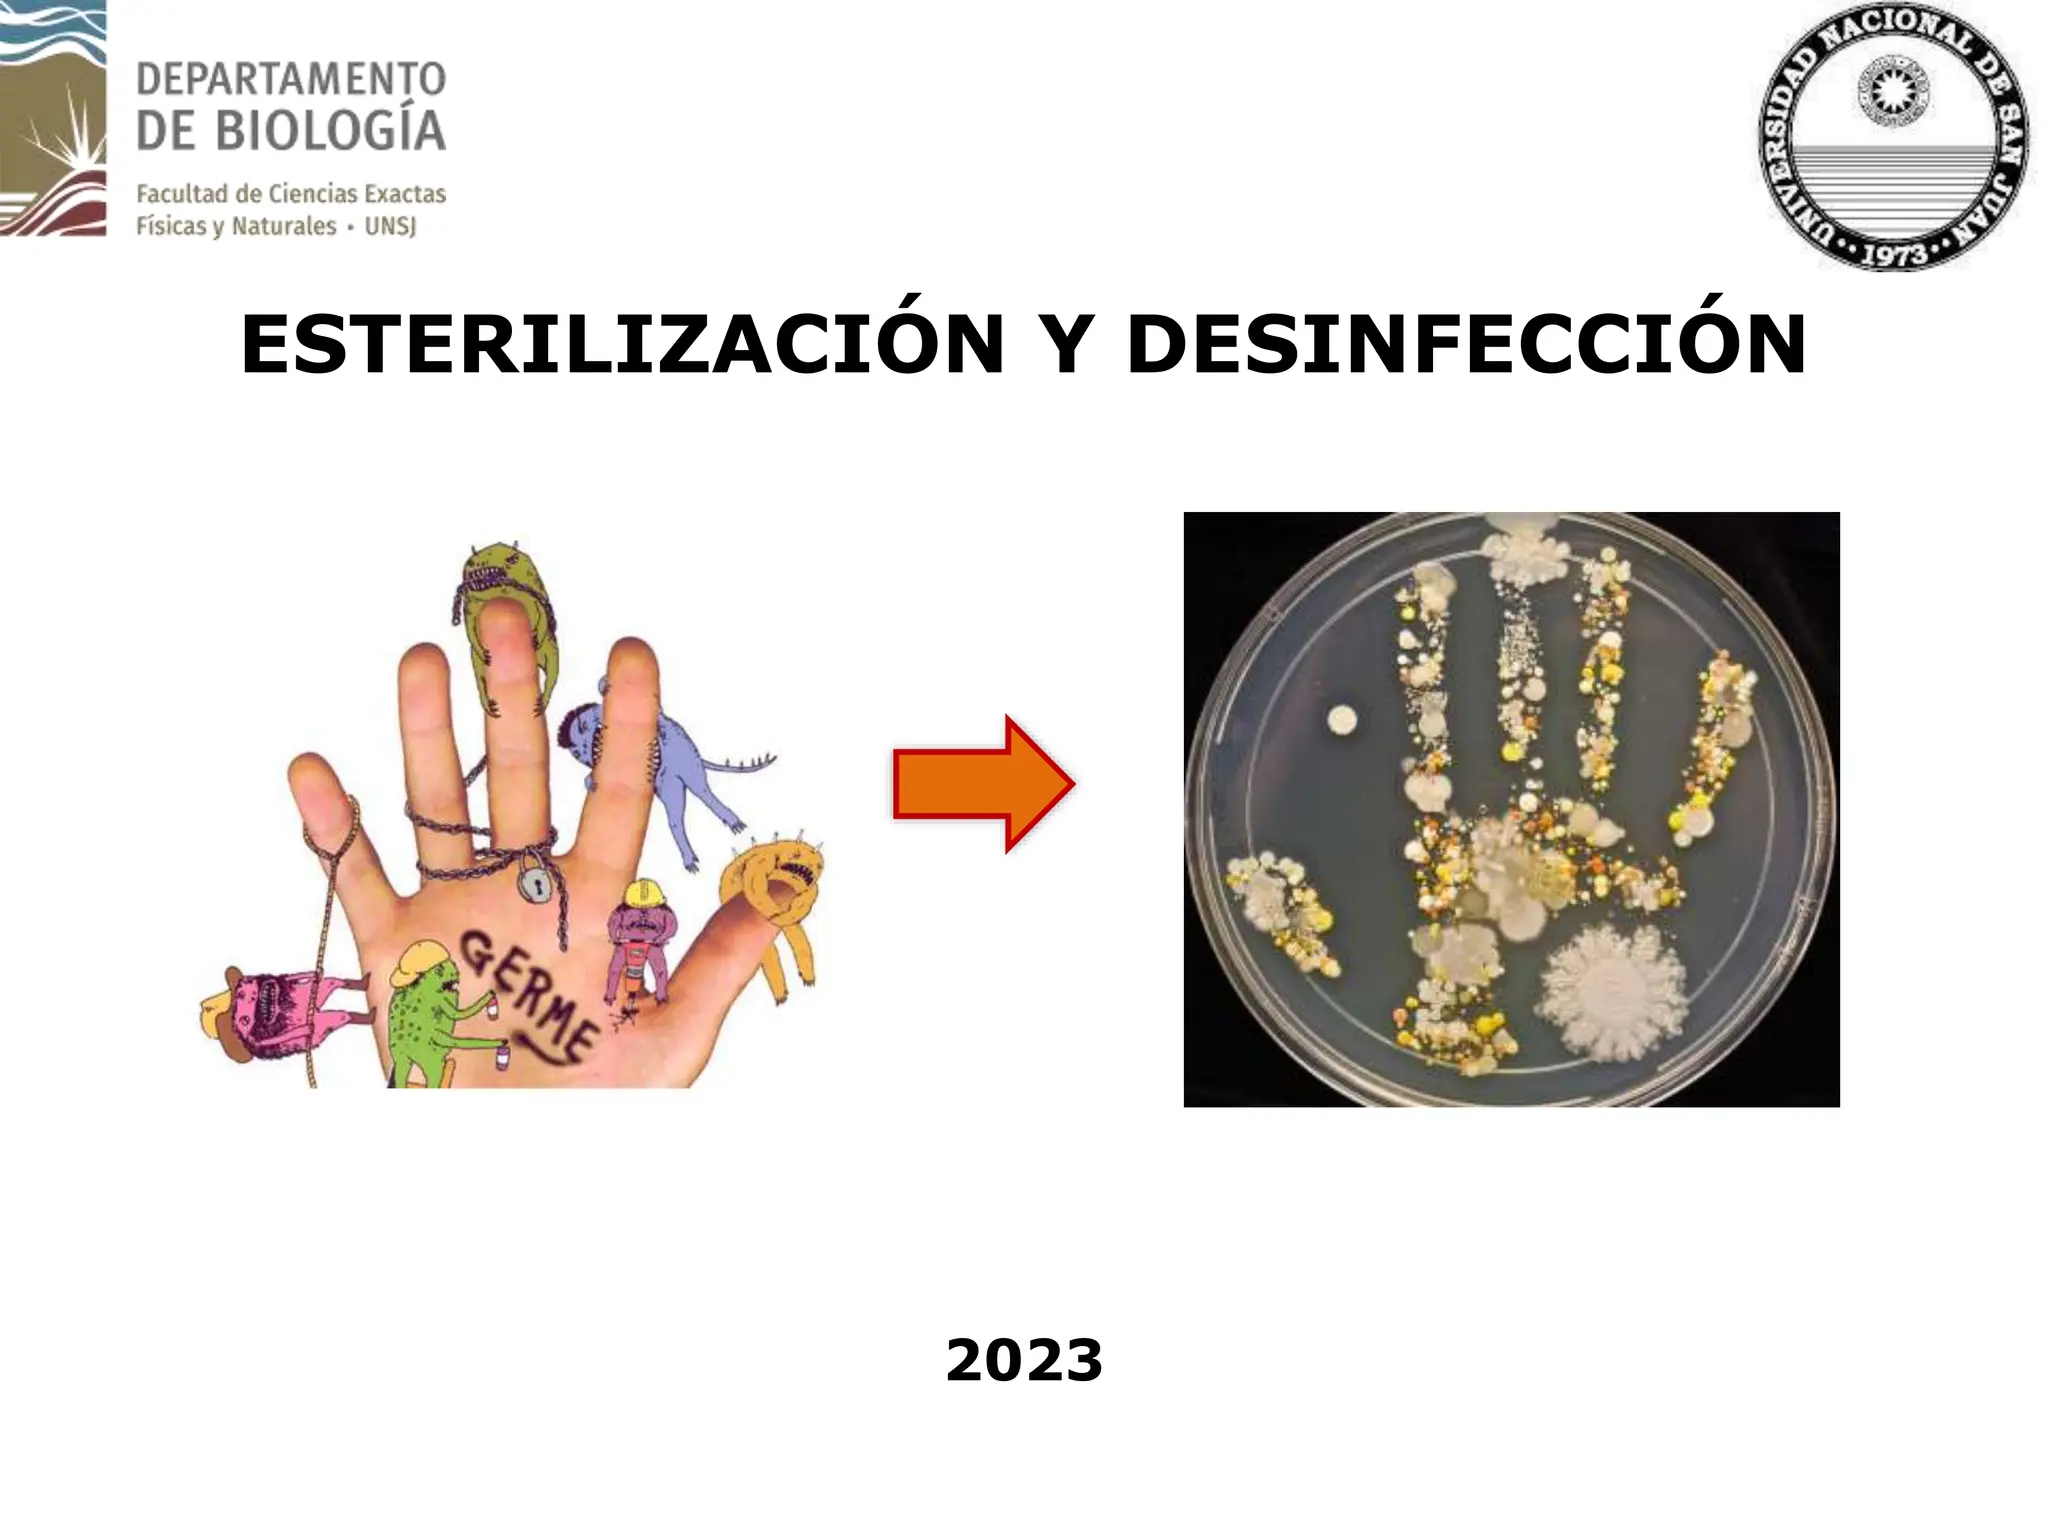

Este documento describe métodos de esterilización y desinfección. Explica que la esterilización destruye todas las formas de vida microbiana mediante agentes físicos o químicos, mientras que la desinfección destruye o inhibe microorganismos con agentes químicos. Luego detalla métodos físicos como el calor húmedo (ebullición, pasteurización, vapor), calor seco, filtración y radiación, así como métodos químicos como agentes esterilizantes (formaldehído,